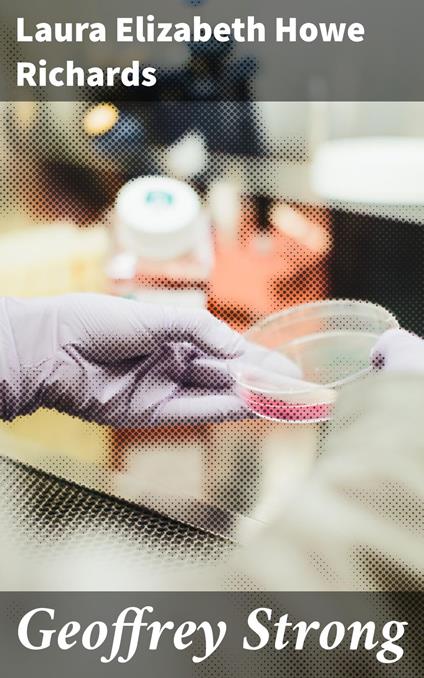

L’articolo è stato aggiunto alla lista dei desideri
IBS.it, l'altro eCommerce
Geoffrey Strong
Cliccando su “Conferma” dichiari che il contenuto da te inserito è conforme alle Condizioni Generali d’Uso del Sito ed alle Linee Guida sui Contenuti Vietati. Puoi rileggere e modificare e successivamente confermare il tuo contenuto. Tra poche ore lo troverai online (in caso contrario verifica la conformità del contenuto alle policy del Sito).
Grazie per la tua recensione!
Tra poche ore la vedrai online (in caso contrario verifica la conformità del testo alle nostre linee guida). Dopo la pubblicazione per te +4 punti
Altre offerte vendute e spedite dai nostri venditori



Tutti i formati ed edizioni
Promo attive (0)
In "Geoffrey Strong," Laura Elizabeth Howe Richards crafts a compelling narrative that delves into the intricate intersections of personal resilience and societal expectation. The novel, set against the backdrop of early 20th-century American life, deftly weaves rich character development with poignant moral dilemmas, exploring themes of integrity, ambition, and the pursuit of happiness. Richards employs a vivid literary style that combines lyrical prose with sharp social commentary, reflecting her deep engagement with contemporary issues surrounding gender and class during her time, making it a noteworthy contribution to American literature. Laura Elizabeth Howe Richards, a prominent figure in the literary world and an advocate for women's rights, drew upon her rich background'Äîincluding her lineage as the daughter of renowned author and abolitionist Anna Elizabeth Richards'Äîto infuse her writing with a sense of purpose and advocacy. Her extensive involvement in social issues and her experiences'Äîas both a writer and speaker'Äîshaped her belief in the power of narratives to inspire change, and "Geoffrey Strong" stands as a testament to her commitment to championing the human spirit. For readers seeking a multifaceted exploration of character and ethics, "Geoffrey Strong" is not to be missed. It invites a thoughtful reflection on the resilience of individuals in the face of adversity, making it an essential read for those interested in literature that challenges and uplifts.
L'articolo è stato aggiunto al carrello
Formato:
Gli eBook venduti da IBS.it sono in formato ePub e possono essere protetti da Adobe DRM. In caso di download di un file protetto da DRM si otterrà un file in formato .acs, (Adobe Content Server Message), che dovrà essere aperto tramite Adobe Digital Editions e autorizzato tramite un account Adobe, prima di poter essere letto su pc o trasferito su dispositivi compatibili.
Cloud:
Gli eBook venduti da IBS.it sono sincronizzati automaticamente su tutti i client di lettura Kobo successivamente all’acquisto. Grazie al Cloud Kobo i progressi di lettura, le note, le evidenziazioni vengono salvati e sincronizzati automaticamente su tutti i dispositivi e le APP di lettura Kobo utilizzati per la lettura.
Clicca qui per sapere come scaricare gli ebook utilizzando un pc con sistema operativo Windows
L’articolo è stato aggiunto alla lista dei desideri